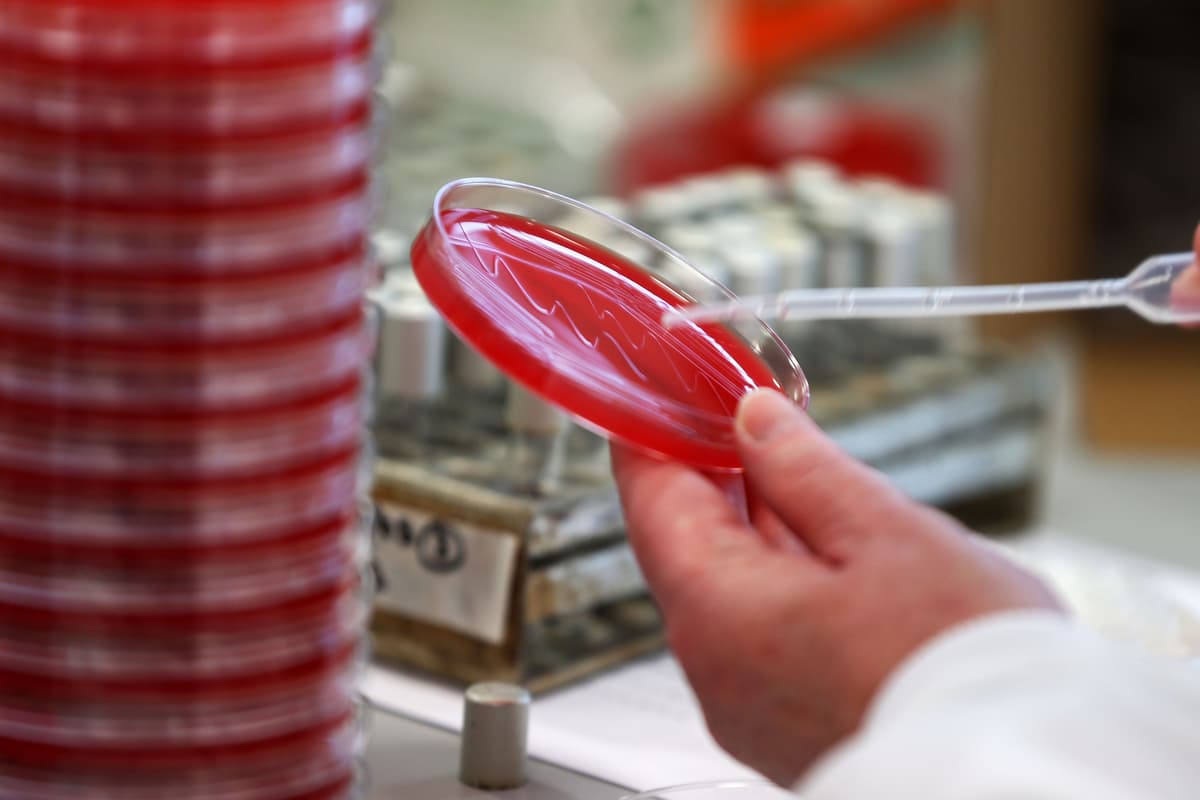
Researchers developing lateral flow test to detect brain tumours Researchers developing lateral flow test to detect brain tumours

Ethereum’s Ether (ETH) token continued its losing streak versus Bitcoin (BTC) for the fifth day in a row as BTC’s price jumped above $30,000 for the first time since June 2022.
ETH/BTC bullish reversal fails midway
On April 11, the ETH/BTC pair dropped nearly 1.6% to 0.0634 BTC to retest multi-month lows.
ETH/BTC level is down 6.75% from its local peak of 0.0679 BTC set six days ago. It is also just 2% above the pair’s local low of 0.0622 BTC from March 20, showing that Ether’s bullish reversal attempt versus Bitcoin is near failure.
Interestingly, institutional interest also appears more gravitated toward Bitcoin than Ethereum, according to CoinShares’ weekly report. It shows that the Bitcoin-focused investment funds witnessed inflows worth $56 million in the week ending April 7.

In comparison, the Ethereum-based funds received only $600,000 despite the hype around its long-awaited Shanghai hard fork on April 12.
Another ETH price rebound attempt ahead?
ETH/BTC’s ongoing decline has prompted it to retest its multi-month ascending trendline support (buy zone) near 0.0635 BTC for a potential price rebound toward its descending trendline resistance (sell zone) near 0.0750 BTC.
In other words, a 16.5% price rally by June, as covered in previous analysis.

The bullish reversal outlook takes cues from ETH/BTC’s price rebound in July 2022 after testing the same ascending trendline as support. Notably, the pair rose by about 60% to reach the descending trendline resistance near 0.0856 BTC.
Related: 3 reasons why Ethereum price can reach $3K in Q2
Conversely, a decisive break below the ascending trendline support would raise ETH/BTC’s possibility to eye its 200-week exponential moving average (200-week EMA; the blue wave) near 0.0563 BTC, down about 10% from current price levels.

Like the ascending trendline support, the 200-week EMA was instrumental in stopping Ether’s price decline versus Bitcoin in July 2022. This makes it the most probable downside target in the coming months.
This article does not contain investment advice or recommendations. Every investment and trading move involves risk, and readers should conduct their own research when making a decision.